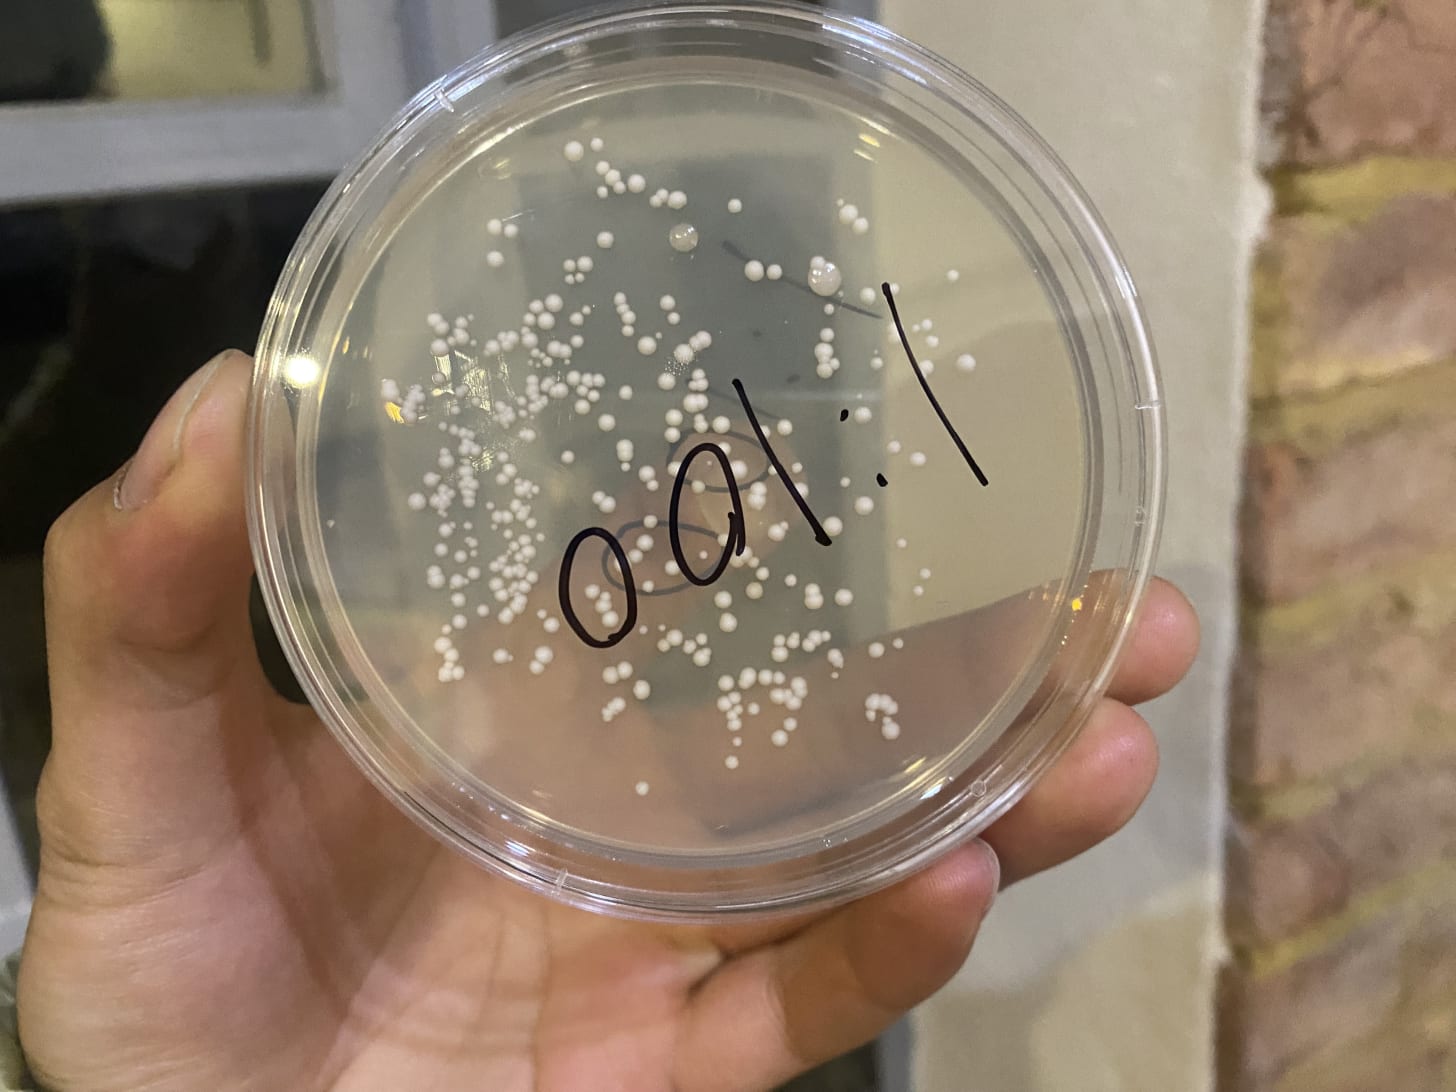

In my last post, I tried to grow yeast colonies at different concentrations. I wanted to find the sweet spot that would give me an easy countable number of colonies, to make it amenable for further testing. After three days of growing, here are the results!
The stock solution - too many colonies.
The 1:10 concentration - contaminated.
The 1:100 concentration - countable, but a lot.
The 1:1000 concentration - just right, baby!
The 1:10000 concentration - too little.
For the next part, I’m going to use blast some of the 1:1000 concentration with UV and test to see how much dose kills it.
Thanks again to David Jordan at Living Physics for the supervision.
.png)

![MirageOS Powers Docker Desktop [2022]](https://mirage.io/img/blog-VPNKit.png)


